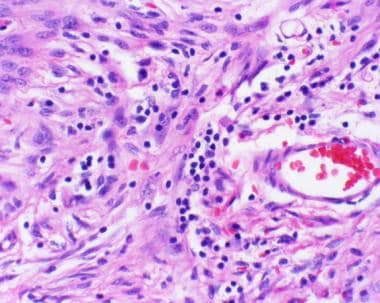
多形性黄色星形细胞瘤

多形性黄色星形细胞瘤(PXA)最初被描述为黄色肉瘤,直到人们认识到这些肿瘤不仅生长缓慢,而且产生胶质纤维酸性蛋白(GFAP)。作为这些发现的结果,该肿瘤被作为星形细胞瘤的一个子集,并被命名为多形性黄色星形细胞瘤,这反映了其大的、通常多核的细胞的组织学外观,具有丰富的泡沫状细胞质和星形细胞表型。
起初,多形性黄色星形细胞瘤被认为是良性肿瘤,类似于一级毛细胞星形细胞瘤然而,随后对这些肿瘤的随访证明,高达20%的多形性黄色星形细胞瘤有多年复发的趋势,并发展为浸润性肿瘤或更快的复发,这种趋势现在已被国际卫生组织(世卫组织)认定为二级。
病理生理学和流行病学
多形性黄色星形细胞瘤占全部星形细胞肿瘤的不到1%,其病因的病理机制知之甚少。没有种族优势是众所周知的,在美国也没有性别优势。然而,多形性黄色星形细胞瘤较常见于人生的前30年,在二个十年出现明显的高峰。
临床特征
文献表明,大多数多形性黄色星形细胞瘤患者表现为癫痫。有时评估期很长,长达数年,但大多数患者是在癫痫发作后6个月内被诊断出来的。其他患者出现头痛,但定位神经症状是少见的。肿瘤较常见于颞叶或额叶,但中枢神经系统(CNS)的全部区域都有病变。
影像研究
据报道,多形性黄色星形细胞瘤有一系列的影像学表现,从带有附壁结节的囊性肿块到附着在脑表面的实体瘤。硬膜附着可能与脑膜增厚有关。囊性病变的结节位于表面和皮下。囊肿可能与邻近的软组织有一个弥漫浸润的界面。
多形性黄色星形细胞瘤是一种生长缓慢的肿瘤,继发表现为惰性生长,包括颅骨内层的扇形侵蚀。在计算机断层扫描中,多形性黄色星形细胞瘤可以是囊性的(43%)或实性的(15%)。 肿瘤的囊性部分密度低,而实性部分呈混合密度。附壁结节低密度,对比度增强。囊肿壁可以增强,也可以不增强。
病理
下面简要讨论多形性黄色星形细胞瘤的组织学、免疫组织化学和分子学发现。
组织学发现
多形性黄色星形细胞瘤的特征是细长的梭形细胞,胞质嗜酸性,偶尔有巨细胞,其中一些可能表现为泡沫状或黄色改变(见下图)。嗜酸性颗粒体,一种病因未知的退化性细胞现象,也可能在毛细胞星形细胞瘤中遇到,几乎总是存在。 这些肿瘤中的大多数还表现出细胞周网状蛋白,这一特征最初被认为是诊断性的,但后来发现不太可靠。网状蛋白对应于与每个肿瘤细胞相关的基底膜。淋巴细胞和浆细胞浸润也是常见的发现。

多形性黄色星形细胞瘤的特征是大的多核细胞,胞质呈泡沫状,通常混有一群较小的纤维细胞。肿瘤细胞的细胞边界通常独特。(苏木精和曙红,20倍原始放大倍数。)
单核炎性细胞浸润对于多形性黄色星形细胞瘤并不少见。(苏木精和曙红,40×原始放大倍数。)

嗜酸性颗粒体的频繁出现通常是阻止病理学家从较高级别的肿瘤向较低级别的肿瘤发展的有用线索,如多形性黄色星形细胞瘤(PXA)或毛细胞星形细胞瘤。(苏木精和曙红,40×原始放大倍数。)

多形性黄色星形细胞瘤经常表现为细胞周围网状蛋白。(Wilders网状蛋白,40倍原放大。)

多形性黄色星形细胞瘤可能在诊断时或多年随访后显示坏死区域,这一特征被国际卫生组织(世卫组织)认为符合“具有间变性特征的多形性黄色星形细胞瘤”的诊断标准(苏木精和曙红,20倍原始放大倍数。)
免疫组织化学
多形性黄色星形细胞瘤有显示非磷酸化神经丝蛋白免疫反应细胞的强烈倾向。事实上,这些肿瘤中的一些已经被描述为神经节细胞胶质瘤的一个组成部分,但是多形性黄色星形细胞瘤和神经节细胞胶质瘤之间不太可能有更多的关系。神经丝蛋白定位可能是区分这种肿瘤和巨细胞胶质母细胞瘤的一种合适方法。CD34也可见于这些肿瘤。
分子病理学
多形性黄色星形细胞瘤有染色体异常的报告,迄今为止较大的研究发现9号染色体缺失(较常见的影响9p21基因座)是较常见的,但也注意到包括17、8、18和22号染色体缺失(按频率顺序)在内的异常,X、7、9q、20、4、5和19号染色体(按频率顺序)有所增加。随后的一项研究也注意到了另外4例多形性黄色星形细胞瘤的不规则得失,它们不对应于上述位点。最近,在大约50%的PXA中描述了BRAFv600e突变。
预后
一组72例多形性黄色星形细胞瘤患者的5年生存率为72%,10年生存率为61%。这些肿瘤偶尔会出现侵袭性特征,包括大细胞核、活跃的有丝分裂活性和肿瘤坏死区域。轻快的Ki-67标记指数预后不良。
具有间变性特征的多形性黄色星形细胞瘤的诊断仍然是一个有争议的名称,因为根据较新的世卫组织指南,没有足够的经验来充分识别它。然而,世卫组织指出,每10个高功率场显示5个或更多有丝分裂的肿瘤、坏死和小细胞的相对增加是复发肿瘤中更常见的特征。 国际卫生组织没有给这种肿瘤的变异体指定具体的等级。


